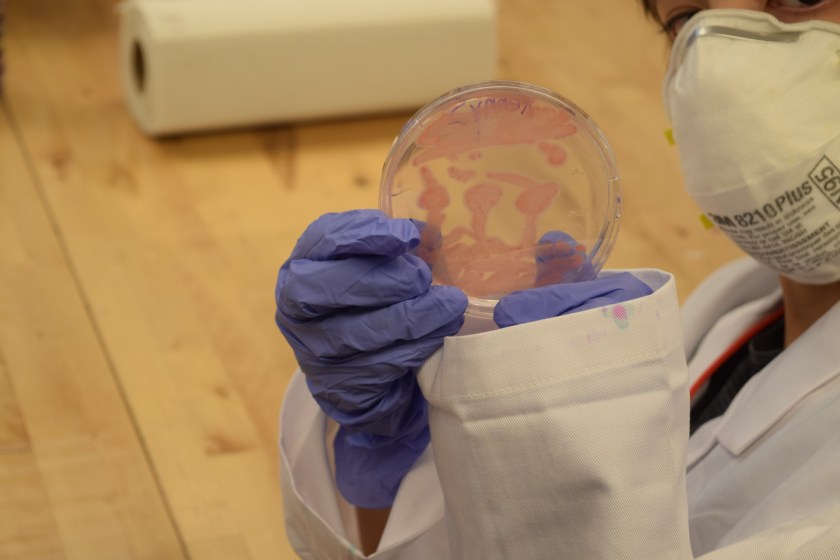
DSC_0813.JPG

As part of the Digital Culture Summer Institute, the SANDS lab organized a bioart module for junior and high school students. Working with Cassandra Barrett and Kat Fowler, we developed a week-long summer camp course that invites students to create petri dish art using bacteria and antibiotic substances.
As part of the Digital Culture Summer Institute, the SANDS lab organized a bioart module for junior and high school students. Working with Cassandra Barrett and Kat Fowler, we developed a week-long summer camp course that invites students to create petri dish art using bacteria and antibiotic substances.
Our design studio was recently approved for BSL-1 (biosafety level 1) clearance, which means we can now (officially) work with minimally risky bacteria and procedures. Fun fact: we might be the first design lab to get this clearance through the ‘proper’ layers of paperwork and inspections at our University!
Our work embraces the DIYbio movement, which aims to make biology accessible outside of professional laboratories. So during the first day of camp, we showed the students how to sterilize lab equipment with a pressure cooker. According to the CDC guidelines, this means the materials must be kept at 121°C and 15psi for 30 minutes. It’s usually a pretty exciting 30 minutes to be watching the pressure cooker.
The next few days of the camp were spent practicing aseptic (sterile) lab technique to streak plates with different pigmented bacteria. We used our trusty old DIY incubator that we made in-house to culture our art at 26C.

We used several regular antibiotics (Ampicillin and Streptomycin) as well as antibiotic items the students brought from home to shape the growth of the bacteria. Essentially, we did the Kirby–Bauer diffusion test for antibiotic sensitivity, whereby growth is hindered around the effective antibiotics.
Our students brought an impressive and very creative range of substances to test for antibiotic properties, including handsoap, pennies, dog antibiotics, neosporin (very effective), tylenol, and toothpaste (not very effective at killing bacteria it turns out!).
We also added food coloring to our media to add a background color to the petri dish art.
For the final project, we asked the students first to sketch out the layout for their bacteria art piece, including what bacteria, background color, and antibiotic substances they wanted to use on their petri dishes. Can we say we did rapid lo-fi prototyping for biology 🙂 ?

The resulting bacteria images inspired us to write bioart haikus, and some of these were pretty deep.
Finally, the students used a graphic design program to convert their favorite petri dish images into stencils for vinyl cutting and screenprinting. The last day day of screenprinting was chaotic and messy, but order emerged just like the haiku said 😉
Huge thanks to everyone who helped run this awesome class, and to the creative and thoughtful students who are now excited to take a bio course at their schools even if they don’t get a printed T-shirt out of it next time.

































